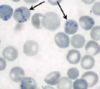

Red Blood Cell Structure and Function Flashcards
(41 cards)
Identify Relevant Features of this Image


Plasma vs. Hematocrit

Blood Volume vs. Fluid Volume in the Body

Iron Transport and Metabolism

What are the smallest cells in the body?
Eryrthocytes = RBC’s = smallest cells within the body.
Structure of Erythrocytes

What determines Blood Groups?

Blood Types

Blood types you can recieve

Biochemical Function of Erythrocytes

Physiological Function of Erythrocytes

Poisons of Normal Physiological Functioning of Erythrocytes

Main Transporte of CO2 and mechanism

Role of Carbonic Anhydrase

Explanation of Choloride Shift

Another view of Chloride Shift

What is a reticulocyte?
Wright Stain?

Development of Erythrocytes

Pluripotential Hematopoetic Stem Cell
Requires Physiological Regulation

Homeostasis

Erythropoetin Mechanism for regulating the rate of Erythropoesis

Regulation of Mass of RBC’s

What Triggers increase in RBC production

Where is Erythropoetin Produced? And How?